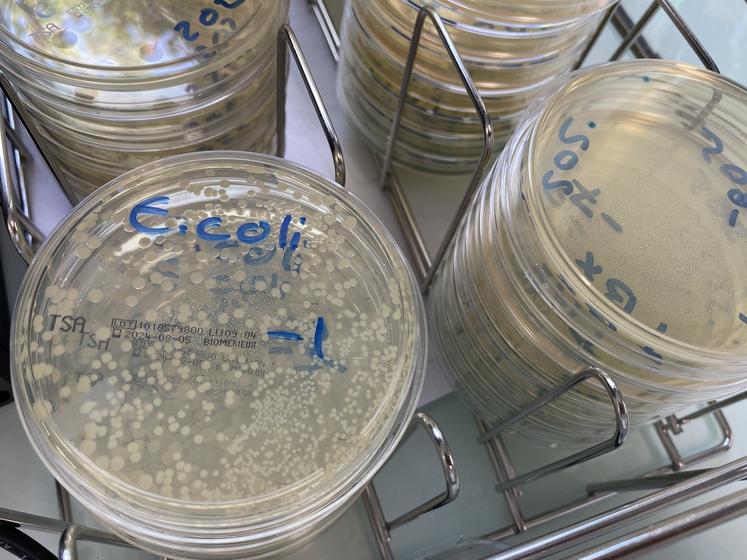
Une recherche d'Escherichia coli dans un échantillon alimentaire.

Les entreprises d'ici
À Champdeniers, Qualyse œuvre pour un territoire "sain et sûr"
Premier laboratoire d'analyses de son vaste territoire, Qualyse étend ses domaines d'expertise de la santé animale à la sécurité alimentaire, en passant par l'hydrologie et l'environnement.
Premier laboratoire d'analyses de son vaste territoire, Qualyse étend ses domaines d'expertise de la santé animale à la sécurité alimentaire, en passant par l'hydrologie et l'environnement.

Le laboratoire Qualyse trouve son origine dans la mise en œuvre de la lutte contre les épizooties, avec la création des laboratoires des services vétérinaires, en 1945.
En 2008, la fusion du Lasa de Champdeniers (laboratoire départemental vétérinaire) avec le laboratoire départemental des eaux de Niort et le laboratoire départemental d'analyse de La Rochelle donne naissance au Lasat.
Les services d'analyses sont alors spécialisés par site : La Rochelle est dédiée à l'eau et l'environnement, Champdeniers devient le pôle " Qualité et sécurité des aliments ", compétent en microbiologie et chimie alimentaire et Niort le pôle " Santé animale ", compétent en sérologie, prophylaxie, ESB et biologie moléculaire.
En 2016, l'ensemble des activités deux-sévriennes sont regroupées à Champdeniers, dans la zone d'activité de Montplaisir.